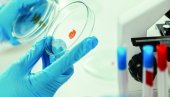
ТЕСТ КОЈИ И ПРЕ СИМПТОМА ПОКАЗУЈЕ ПРИСУСТВО РАКА: Како су научници дошли до утврђивања абнормалности

КОЈИ СУ УЗРОЦИ ПОВИШЕНОГ ДОЊЕГ ПРИТИСКА: Кардиолог Синиша Павловић објашњава
УЗРОК повишеног доњег - дијастолног притиска је задржавање воде у организму, што је честа последица претераног уноса соли, о слабостима овог обољења за "Новости" говори професор доктор Синиша Павловић, кардиолог.

Фото З. Јовановић
Узрок повишеног доњег - дијастолног притиска је задржавање воде у организму, што је честа последица претераног уноса соли. Други значајан узрок и непосредно повезани са овим механизмом је гојазност. Мање је познато да гојазне особе имају управо значајно задржавање натријума, и као последицу тога повећан притисак. Изузетно значајан узрок је и континуирани стрес, објашњава доктор Павловић.
Као могућ узрок се наводи и неумерен унос алкохола, мада је људима који злоупотребљавају алкохол прилично тешко објаснити појам "умерен". Углавном повишени дијастолни притисак имају особе које немају никакву или врло слабу физичку активност. Неки од лекова могу да имају ефекат на дијастолни притисак, а од оних који се широко примењују су нестероидни антиреуматици и антидепресиви. Већ дуго је познато да пораст овог притиска може бити и последица коришћења оралних антиконтрацептивних средстава, прецизира кардиолог.
Klikni na zvezdicu u gornjem desnom uglu i zaprati Novosti na Google News platformi


РУСИЈА СЕ ХИТНО ОГЛАСИЛА О СРБИЈИ: Песков коментарисао однос Москве и Београда
РУСИЈА и Србија имају партнерство које омогућава Москви и Београду да разговарају о најхитнијим питањима, али Србија бира свој пут развоја, изјавио је Дмитриј Песков, портпарол руског лидера.
05. 06. 2026. у 11:49

НЕМАЧКА ХИТНО ПОЗВАЛА РУСИЈУ: Путине, време је...
МИНИСТАР спољних послова Немачке, Јохан Вадефул, позвао је руског председника, Владимира Путина, да покрене преговоре о миру у Украјини уз учешће Европе, преносе немачки медији.
05. 06. 2026. у 09:53

НАСТАЈЕ НОВА ДРЖАВА? Српске комшије се уједињују са суседима - за моћну државу од 22 милиона душа и 272.200 км²
"УНИОНИСТИЧКИ покрет је одувек постојао и он је и даље жив унутар нашег друштва. Несумњиво је да је ова дискусија легитиман део политичког процеса у земљи. Ја лично никада не бих могао да гласам против уједињења."
02. 06. 2026. у 21:24

Коментари (0)